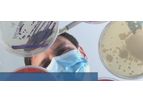
Further Genotyping Kits

- Home
- Companies
Refine by
Industries served
- Energy
- Water and Wastewater
- Monitoring and Testing
- Medical / Health Care
- Environmental
- Agriculture
- Waste and Recycling
- Manufacturing, Other
- Air and Climate
- Oil, Gas & Refineries
- Chemical & Pharmaceuticals
- Soil and Groundwater
- Electronics and Computers
- Construction & Construction Materials
- Food and Beverage
- Mining
- Health and Safety
- Automobile & Ground Transport
- Metal
- Maritime/Shipbuild/Water Transport
- Aerospace & Air Transport
- Plastics & Resins
- Government
- University / Academia / Research
- Defense
- Commercial
- Pulp & Paper
- Communications / Telecom / Datacom
- Logistics
- Packaging
- Textile
- Forestry & Wood
- Real Estate
- Dry Cleaning
- Glassware
- Paint
- Printing
- Furniture
- Leather & Tanning
- Banking & Finance / Insurance / Legal
- Travel & Leisure
- Domestic
- Retail
Environmental Industry Technology
1,500 companies found

Premium
Technologybased inSaskatoon, SASKATCHEWAN (CANADA)
We are scientists, engineers, and environmental experts uniting with one goal: to restore, repair, and improve the world’s soils. Our work is built on decades of field research, proven science, and environmental commitment. We do not just create ...
Monitors petroleum hydrocarbon (PHC) concentrations and soil gas conditions underground, continuously and automatically. Replaces or supplements periodic groundwater sampling — delivering real-time data on plume stability and remediation ...

Premium
Technologybased inRignano S.Arno (Firenze), ITALY
C&G Evaporator is the leading company in the design and production of vacuum evaporators. Water is life, and far too precious a resource to be wasted. We know this well at C&G Evaporator, which is why we create solutions capable of significantly ...
Higher concentration: This evaporator guarantees a higher concentration of the liquid treated, with the aid of a wall scraper system with a lower blade driven by a gear motor. Volumes to be treated up to 1500 lt/g. Volumes processed up to 1500 ...

Technologybased inCwmbran, UNITED KINGDOM
We are a Solar Systems Integrator, which means we cover all aspects of your solar project - from start to completion. And it does not end there, we will monitor your systems and report their performance, plus arrange any future ...
Our Singapore procurement team is dedicated to the best price/quality/warranty solution per project whilst guaranteeing smooth logistics to our project and site ...
Technologybased inAnjou (Québec), QUEBEC (CANADA)
Lithion Technologies has developed a sustainable, robust, and cost-effective solution to produce strategic materials from end-of-life lithium-ion batteries and non-compliant components. These batteries are found in everyday items such as electric ...
Lithion provides its partners with an all-in-one solution. From pick-up to secure transportation and processing of your EV ...

Technologybased inKemptthal, SWITZERLAND
Haelixa is the Swiss knife of traceability solutions: extreme precision and functionality in any scenario. In a world where supply chains have become complex and disruptions have increased, traceability is critical to ensure transparency. While ...

Technologybased inFairfield, CONNECTICUT (USA)
GE is Imagination at work. From jet engines to power generation, financial services to water processing, and medical imaging to media content, GE people worldwide are dedicated to turning imaginative ideas into leading products and services that ...

Technologybased inPeachland, BRITISH COLUMBIA (CANADA)
ZMM Canada Minerals Corp. is a clean technology company specializing in innovative natural zeolite products and solutions. They focus on creating advanced, high-performance, environmentally friendly zeolite solutions tailored to specific customer ...

Technologybased inBroussard, LOUISIANA (USA)
Produced Water Solutions (PWS) is a company specializing in engineering and manufacturing water treatment equipment tailored to specific customer needs and standards. With over 30 years of experience in the produced water industry, PWS provides ...

Technologybased inGentbrugge, BELGIUM
Trevi environmental technology and advice has a multidisciplinary team of more than 150 professionals. This offers you the advantage to solve all your environmental problems with only one partner for the domains of water, air and soil as well as ...
Biological wastewater treatment plants exist in several variations. The most important differences are found in the sludge/water separation process. In a continuous activated sludge system the flocks settle in a clarifier. In a sequencing batch ...

Technologybased inCorpus Christi, TEXAS (USA)
ReadyFlo is an engineering, manufacturing, and field service company for the energy and industrial sectors. We specialize in custom-engineered hydrocarbon measurement and control systems, but our wide range of experience expands to a broad array of ...
LACT units are one of the most critical pieces of equipment in the oil patch – analyzing, measuring and recording unattended oil and gas transactions from the seller to the buyer. These units are found throughout the oil and gas custody ...

Technologybased inBad Langensalza, GERMANY
INTER-ARRAY combines bioanalytics with state-of-the-art microtechnologies, especially in the field of high precision microdispensing. INTER-ARRAY is partner of companies and institutions in the fields of medicine and medical technology, diagnostics, ...
INTER-ARRAY genotyping with microarrays is robust, inexpensive and fast, differentiates between identical and clonally related strains and captures the core genome and varying genes. The combination of rapid genome sequencing of selected isolates ...

Technologybased inMilan, ITALY
Italfarmaco SpA is a private Italian multinational company located in Milan, operating in Italy and abroad in both the pharmaceutical and fine chemical industries through its controlled and/or participated companies. Italfarmaco was establish in ...
As established by the relevant legislation for the Management Health and Safety System (UNI ISO 45001:18), describes the document relative to its own Safety ...

Technologybased inMarseille, FRANCE
We support project holders who enable actors in industry and heavy-duty transport (aviation, maritime, etc.) to decarbonize their activities. Whether green hydrogen, carbon capture and utilization, or heat recovery, discover how to reduce your CO2 ...
We support project holders who enable actors in industry and heavy-duty transport (aviation, maritime, etc.) to decarbonize their activities. Whether green hydrogen, carbon capture and utilization, or heat recovery, discover how to reduce your CO2 ...

Technologybased inNew York, NEW YORK (USA)
LOOKEE® is a team of dedicated professionals who have found incredible benefit and value in technological innovation for health, well-being, and improving quality of life. We believe everyone has the right to a restful night’s sleep and in the ...

Technologybased inAarhus, DENMARK
Welcome to Cordulus - a cutting-edge technology company that delivers hyper-local weather data and powerful AI solutions to a diverse range of customers. The weather is one of the most influential factors in our lives and weather insights can ...
A large road weather station that can handle special sensors to meet your needs. Detailed insights: Get valuable and actionable road status insights from your key locations. Advanced is designed to operate special sensors for winter maintenance. ...

Technologybased inNaples, FLORIDA (USA)
Enveric Biosciences is leveraging its discovery engine and intellectual property portfolio to identify and build the next generation of psychedelic and cannabinoid medicines for the mind and body. By harnessing the power of synthetic biology and ...
Enveric Biosciences focuses on synthesizing novel, tailored and highly differentiated derivative molecules based on classic psychedelics such as psilocybin, N,N-dimethyltryptamine (DMT), mescaline and ...

Technologybased inZürich, SWITZERLAND
Biosimo Chemicals is a pioneering chemical engineering startup dedicated to developing innovative solutions for producing bio-based platform chemicals. The company emphasizes the creation of sustainable and environmentally-friendly chemicals by ...

Technologybased inSomerville, MASSACHUSETTS (USA)
Eden is dedicated to providing scalable solutions that harness Earth's natural resources while minimizing environmental impact. By utilizing 100% renewable energy, Eden deploys its innovative Electrical Reservoir Stimulation Technology, which ...
Subsurface resource recovery that’s more precise, sustainable, and effective. Our Electrical Reservoir Stimulation Technology makes it ...

Technologybased inOrlando, FLORIDA (USA)
PureCycle is revolutionizing recycled polypropylene into a renewable resource through our unprecedented purification process. We are revolutionizing plastic waste into a renewable resource. We are PureCycle and we’re changing the game when it comes ...
The game-changing polypropylene recycling technology that PureCycle uses consists of seven main process stages that help close the loop on plastic waste while making recycled plastics more accessible at scale. The process incorporates ...

Technologybased inCambridge, ONTARIO (CANADA)
UTComp specializes in advanced, non-destructive testing (NDT) methods for the inspection of fiber-reinforced polymer (FRP) composite equipment. Their UltraAnalytix Inspection system provides data-driven assessments to predict the remaining service ...
Fast, reliable, cost-effective NDT inspection and engineering services for all your FRP composite industrial equipment, including piping, storage vessels, ducting, scrubbers, vent stacks, fan impellers, FRP wrapping repairs and more. ...